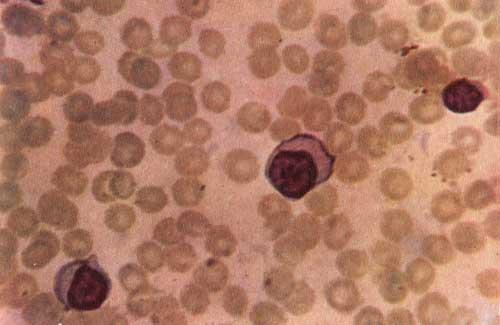

Другие названия и синонимы
B27 Infectious mononucleosis, B27.
Описание
Инфекционный мононуклеоз - инфекция, вызывающая увеличение лимфатических узлов и воспаление горла, от которой в основном страдают подростки и молодые люди. Чаще всего наблюдается в возрасте от 12 до 20 лет. Пол, генетика, образ жизни значения не имеют.
Инфекционный мононуклеоз еще называют «болезнью поцелуев», потому что она чаще всего наблюдается в подростковом возрасте и ранней молодости и передается через слюну. Еще одно название болезни - лимфоидно-клеточная ангина, обусловлено тем, что в симптомы входит опухание лимфатических узлов и высокая температура.
Симптомы.
Вначале инфекционный мононуклеоз можно напоминать тонзиллит, но это намного более тяжелая и продолжительная болезнь. Инфекционный мононуклеоз вызывает вирус Эпштейна-Барр (ВЭБ). Он поражает лимфоциты, белые кровяные клетки, которые отвечают за борьбу с инфекцией. ВЭБ - очень распространенный вирус, и к 50-му году жизни 9 из 10 человек уже инфицированы. Симптомы могут быть следующими:
• высокая температура и потливость;
• сильнейшая боль в горле, вызывающая трудности при глотании;
• опухшие миндалины, часто покрытые плотным серовато-белым налетом;
• увеличенные и болезненные лимфатические узлы на шее, в подмышках и в паху;
• боли в животе из-за увеличенной селезенки.
Характерны также плохой аппетит, потеря веса, головные боли и слабость. У некоторых людей боль в горле и высокая температура проходят быстро, а остальные симптомы исчезают в течение месяца.
Диагностика.
Врач диагностирует инфекционный мононуклеоз по наличию воспаления в горле, увеличенным лимфатическим узлам и высокой температуре. Для подтверждения диагноза требуются анализы крови на антитела к ВЭБ.
Лечение.
Пока не разработано специального лечения инфекционного мононуклеоза, но проявление симптомов можно снизить самыми простыми мерами: следует пить больше жидкости комнатной температуры и принимать анальгетики, отпускаемые без рецепта, такие как парацетамол, которые будут снижать температуру и уменьшать боли. После болезни следует избегать любых силовых спортивных упражнений из-за риска разрыва увеличенной селезенки.
Почти все переболевшие инфекционным мононуклеозом полностью выздоравливают. Но у некоторых людей это занимает больше времени, а слабость сохраняется еще несколько недель или месяцев после исчезновения остальных симптомов.
Если человек переболел инфекционным мононуклеозом один раз, даже бессимптомно, то он приобретает иммунитет к этой болезни на всю жизнь.
Инфекционный мононуклеоз еще называют «болезнью поцелуев», потому что она чаще всего наблюдается в подростковом возрасте и ранней молодости и передается через слюну. Еще одно название болезни - лимфоидно-клеточная ангина, обусловлено тем, что в симптомы входит опухание лимфатических узлов и высокая температура.
Симптомы.
Вначале инфекционный мононуклеоз можно напоминать тонзиллит, но это намного более тяжелая и продолжительная болезнь. Инфекционный мононуклеоз вызывает вирус Эпштейна-Барр (ВЭБ). Он поражает лимфоциты, белые кровяные клетки, которые отвечают за борьбу с инфекцией. ВЭБ - очень распространенный вирус, и к 50-му году жизни 9 из 10 человек уже инфицированы. Симптомы могут быть следующими:
• высокая температура и потливость;
• сильнейшая боль в горле, вызывающая трудности при глотании;
• опухшие миндалины, часто покрытые плотным серовато-белым налетом;
• увеличенные и болезненные лимфатические узлы на шее, в подмышках и в паху;
• боли в животе из-за увеличенной селезенки.
Характерны также плохой аппетит, потеря веса, головные боли и слабость. У некоторых людей боль в горле и высокая температура проходят быстро, а остальные симптомы исчезают в течение месяца.
Диагностика.
Врач диагностирует инфекционный мононуклеоз по наличию воспаления в горле, увеличенным лимфатическим узлам и высокой температуре. Для подтверждения диагноза требуются анализы крови на антитела к ВЭБ.
Лечение.
Пока не разработано специального лечения инфекционного мононуклеоза, но проявление симптомов можно снизить самыми простыми мерами: следует пить больше жидкости комнатной температуры и принимать анальгетики, отпускаемые без рецепта, такие как парацетамол, которые будут снижать температуру и уменьшать боли. После болезни следует избегать любых силовых спортивных упражнений из-за риска разрыва увеличенной селезенки.
Почти все переболевшие инфекционным мононуклеозом полностью выздоравливают. Но у некоторых людей это занимает больше времени, а слабость сохраняется еще несколько недель или месяцев после исчезновения остальных симптомов.
Если человек переболел инфекционным мононуклеозом один раз, даже бессимптомно, то он приобретает иммунитет к этой болезни на всю жизнь.
|
|
Связанные заболевания
Связанные стандарты мед. помощи
- Стандарт специализированной медицинской помощи детям при инфекционном мононуклеозе тяжелой степени тяжести
- Стандарт специализированной медицинской помощи детям при хронических герпесвирусных инфекциях
- Стандарт специализированной медицинской помощи детям при инфекционном мононуклеозе средней степени тяжести
- Стандарт первичной медико-санитарной помощи детям при инфекционном мононуклеозе легкой степени тяжести
|